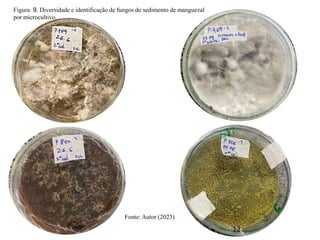
Figura 9. Diversidade e identificação de fungos do sedimento de manguezal
por microcultivo.
Fonte: Autor (2023)
12
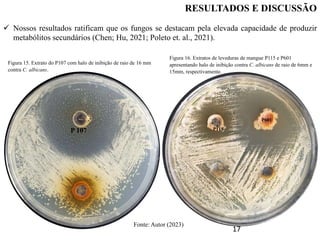
RESULTADOS E DISCUSSÃO
17
 Nossos resultados ratificam que os fungos se destacam pela elevada capacidade de produzir
metabólitos secundários (Chen; Hu, 2021; Poleto et. al., 2021).
P 107
Figura 15. Extrato do P107 com halo de inibição de raio de 16 mm
contra C. albicans.
P601
P115
Figura 16. Extratos de leveduras de mangue P115 e P601
apresentando halo de inibição contra C. albicans de raio de 6mm e
15mm, respectivamente.
Fonte: Autor (2023)
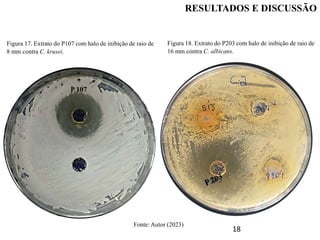
18
Figura 17. Extrato do P107 com halo de inibição de raio de
8 mm contra C. krusei.
Figura 18. Extrato do P203 com halo de inibição de raio de
16 mm contra C. albicans.
P 107
Fonte: Autor (2023)
RESULTADOS E DISCUSSÃO
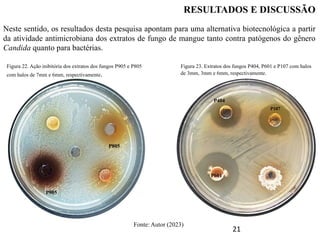
21
Neste sentido, os resultados desta pesquisa apontam para uma alternativa biotecnológica a partir
da atividade antimicrobiana dos extratos de fungo de mangue tanto contra patógenos do gênero
Candida quanto para bactérias.
RESULTADOS E DISCUSSÃO
P404
P601
P107
P905
P805
Figura 23. Extratos dos fungos P404, P601 e P107 com halos
de 3mm, 3mm e 6mm, respectivamente.
Figura 22. Ação inibitória dos extratos dos fungos P905 e P805
com halos de 7mm e 6mm, respectivamente.
Fonte: Autor (2023)

O documento descreve uma pesquisa sobre o potencial antimicrobiano e antioxidante de extratos de fungos isolados de sedimentos de manguezais em São Luís, Maranhão. Os objetivos foram explorar a diversidade fúngica dos manguezais, caracterizar os fungos em relação às atividades biológicas de seus extratos, e verificar a atividade antimicrobiana e antioxidante dos extratos contra bactérias e leveduras patogênicas. Os resultados mostraram que os extratos de alguns fungos apresentaram atividade antimicro